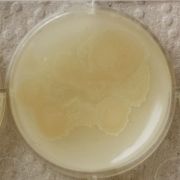
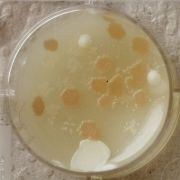
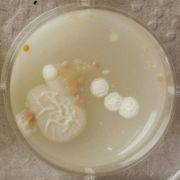

This special page shows all uploaded files.
| Date | Name | Thumbnail | Size | Description | Versions |
|---|---|---|---|---|---|
| 09:10, 19 February 2017 | LACTOCOCCUS 1-d.jpg (file) |  |
901 KB | 1 | |
| 09:10, 19 February 2017 | LACTOCOCCUS 1-c.jpg (file) |  |
806 KB | 1 | |
| 09:09, 19 February 2017 | LACTOCOCCUS 1-b.jpg (file) |  |
820 KB | 1 | |
| 09:07, 19 February 2017 | LACTOCOCCUS 1-a.jpg (file) |  |
791 KB | 1 | |
| 22:36, 17 February 2017 | GAB 3-j pink dot.jpg (file) |  |
2.38 MB | 1 | |
| 22:35, 17 February 2017 | Pink dot.jpeg (file) |  |
752 KB | 1 | |
| 22:33, 17 February 2017 | GAB 3-i.jpg (file) |  |
1.49 MB | 1 | |
| 22:32, 17 February 2017 | GAB 3-h.jpg (file) |  |
1.62 MB | 1 | |
| 22:31, 17 February 2017 | CA 3-b red dot.jpg (file) |  |
1.76 MB | 1 | |
| 22:31, 17 February 2017 | CA 2-b.jpg (file) |  |
1.28 MB | 1 | |
| 22:28, 17 February 2017 | CA 3-a2.jpg (file) |  |
1.33 MB | 1 | |
| 22:27, 17 February 2017 | THERMUS 2-f.jpg (file) |  |
1.06 MB | 1 | |
| 22:26, 17 February 2017 | THERMUS 1-f.jpg (file) |  |
822 KB | 1 | |
| 22:25, 17 February 2017 | THERMUS 3-a.jpg (file) |  |
2.13 MB | 1 | |
| 22:24, 17 February 2017 | THERMUS 2-a.jpg (file) |  |
1.26 MB | 1 | |
| 22:24, 17 February 2017 | THERMUS 1-a.jpg (file) |  |
1.3 MB | 1 | |
| 22:22, 17 February 2017 | THERMUS 1-e.jpg (file) |  |
956 KB | 1 | |
| 22:20, 17 February 2017 | THERMUS 3-d.jpg (file) |  |
2.28 MB | 1 | |
| 22:19, 17 February 2017 | THERMUS 1-d.jpg (file) |  |
900 KB | 1 | |
| 22:19, 17 February 2017 | THERMUS 2-c.jpg (file) |  |
1.21 MB | 1 | |
| 22:18, 17 February 2017 | THERMUS 1-c.jpg (file) |  |
784 KB | 1 | |
| 22:17, 17 February 2017 | THERMUS 2-b.jpg (file) |  |
1.19 MB | 1 | |
| 22:16, 17 February 2017 | THERMUS 1-b2.jpg (file) |  |
826 KB | 1 | |
| 22:16, 17 February 2017 | YM 3-a.jpg (file) |  |
1.93 MB | 1 | |
| 22:15, 17 February 2017 | YM 2-a.jpg (file) |  |
1.46 MB | 1 | |
| 22:13, 17 February 2017 | YM 1-a.jpg (file) |  |
1.06 MB | 1 | |
| 23:03, 16 February 2017 | GAB 2-m2.jpg (file) |  |
1.21 MB | 1 | |
| 23:03, 16 February 2017 | GAB 1-m.jpg (file) |  |
1,014 KB | 1 | |
| 23:01, 16 February 2017 | GAB 2-l.jpg (file) |  |
1.25 MB | 1 | |
| 22:59, 16 February 2017 | GAB 1-l.jpg (file) |  |
1.02 MB | 1 | |
| 18:31, 4 December 2016 | Mikrobielle Batterie.jpg (file) |  |
1.69 MB | 1 | |
| 18:28, 4 December 2016 | Agar as membrane in microbial battery.JPG (file) |  |
3.75 MB | 1 | |
| 22:05, 18 November 2016 | Oyster mushroom 1week.JPG (file) |  |
2.51 MB | Growing Oyster mushrooms. | 1 |
| 22:03, 18 November 2016 | Oyster mushroom preperation.jpg (file) |  |
892 KB | Growing Oyster mushrooms | 1 |
| 22:01, 18 November 2016 | Oyster mushroom.jpg (file) |  |
2.76 MB | Growing Oyster mushroom | 1 |
| 19:57, 18 November 2016 | Gluconacetobacter 1000 times magnification.jpg (file) |  |
533 KB | Looking at microscopic magnification; object of interest: Gluconacetobacter | 1 |
| 19:56, 18 November 2016 | Gluconacetobacter 400 times magnification.jpg (file) |  |
421 KB | Looking at microscopic magnification; object of interest: Gluconacetobacter | 1 |
| 19:54, 18 November 2016 | Gluconacetobacter 100 times magnification.jpg (file) |  |
336 KB | Looking at microscopic magnification; object of interest: Gluconacetobacter | 1 |
| 19:50, 18 November 2016 | Gluconacetobacter 10 times magnification.jpg (file) |  |
376 KB | Looking at microscopic magnification; object of interest: Gluconacetobacter | 1 |
| 00:09, 17 November 2016 | 1-7776 Gluconacetobacter xylinus.jpg (file) |  |
355 KB | 6th petridish of a serial dilution. | 1 |
| 00:06, 17 November 2016 | 1-1296 Gluconacetobacter xylinus.jpeg (file) | |
331 KB | 5th petridish of a serial dilution. | 1 |
| 00:02, 17 November 2016 | 1-216 Gluconacetobacter xylinus.jpg (file) | |
353 KB | 4th petridish of a serial dilution. | 1 |
| 00:00, 17 November 2016 | 1-36 Gluconacetobacter xylinus.jpg (file) | |
328 KB | 3rd petridish in serial delution. | 1 |
| 23:55, 16 November 2016 | 1-6 Gluconacetobacter xylinus.jpg (file) |  |
329 KB | 2nd petridish of a serial delution. | 1 |
| 23:45, 16 November 2016 | 1-1 Gluconacetobacter xylinus.jpg (file) |  |
106 KB | Reverted to version as of 23:33, 16 November 2016 (UTC) | 3 |
| 13:47, 6 November 2016 | Scobi.jpeg (file) |  |
123 KB | 1 | |
| 13:38, 6 November 2016 | Kambucha tea cooling.jpeg (file) |  |
146 KB | 1 | |
| 18:19, 28 October 2016 | Soil bacteria world2.jpg (file) |  |
125 KB | Soil after a week on a medium under a microscope. | 1 |
| 18:16, 28 October 2016 | Soil bacteria world1.jpg (file) |  |
215 KB | Soil after a week on a medium under a microscope. | 1 |
| 18:06, 28 October 2016 | Bacteria on boullion.jpg (file) |  |
209 KB | First time growing bacteria using (beside sugar and agar) water and boullion as ingredients. Only the bacteria in the soil grew. In other places only oil dots appear. | 1 |